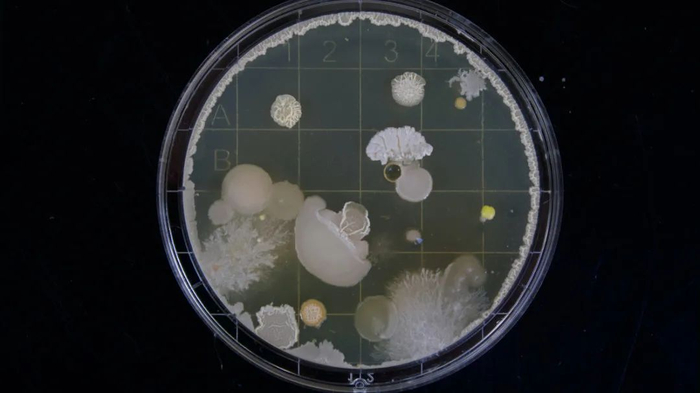

近日,气体发酵初创公司Arkeon宣布申请破产。
该企业创立于2021年,旨在利用二氧化碳生产蛋白质的企业,从矿业巨头ICL、投资了多家培育肉企业的Synthesis Capital等投资者那里筹集了超过1300万美元(约合人民币9342万元)的资金。
产能方面,该公司在维也纳设有试点工厂,通过将二氧化碳和氢气输送到古细菌中,让气体转化为20种蛋白原性氨基酸,再应用于食品领域。
该公司的特色底盘细胞 古细菌(Archaea)
该公司的特色底盘细胞 古细菌(Archaea)在构想中,该公司使用气体代替糖来喂养微生物以降低投入成本,并且简化了灭菌过程,创造了更长的活动时间(污染风险较小),并可能利用废物或副产品气体。

气体蛋白 成本是生死线
然而,在产业化过程中,击倒了Arkeon的也是成本问题。
首先是扩大技术规模的成本很高,该公司所需要的生物反应器较为特殊,需要能有效进行气液混合并实现气体安全处理;其次是负担得起的、可持续的“绿色”氢气来源也具有挑战性。
被寄予厚望的可持续性声明也出现了问题,其第一代工厂并不完全适用于相关标准,这最终导致了Arkeon找不到前进的方法。

上文提及的试点工厂,在2023年建立并配备了150升生物反应器系统,同年该公司启动了3000升生物反应器项目,预计在2024年底投产但至今未有新消息披露。
另一方面,气体发酵的潜力是得到肯定的。只要能突破大规模生产难题,气体蛋白仍然是食品行业一种可行的生产方法。但是要建立成功的企业,需要的远不止是有前途的技术。
据悉,该公司的技术仍在寻求收购,并希望继续实现规模化。

4001102288 欢迎批评指正
Copyright © 1996-2019 SINA Corporation
All Rights Reserved 新浪公司 版权所有
All Rights Reserved 新浪公司 版权所有

